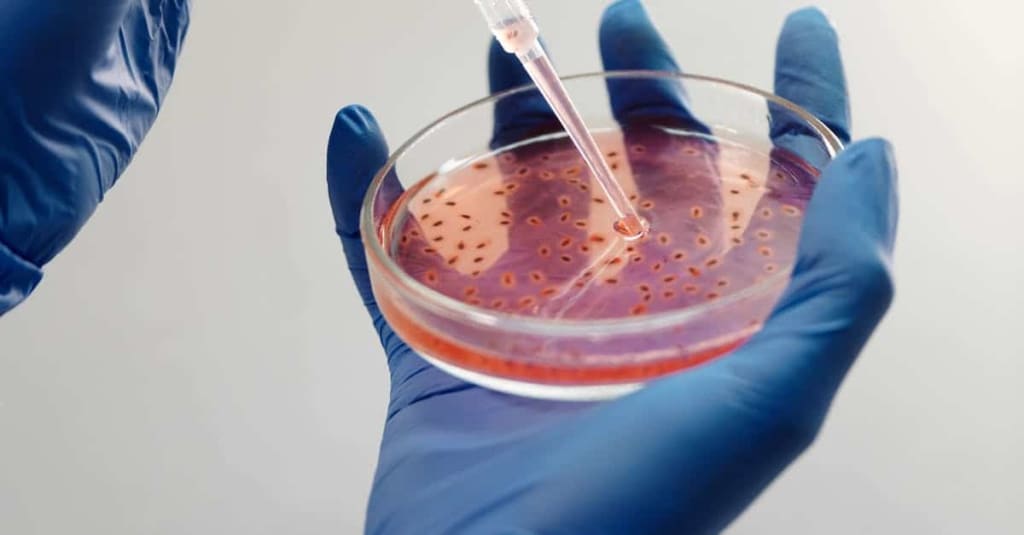

Microbial API: The Rising Demand and Opportunities in Global Microbial API
Microbial API
Microbial active pharmaceutical ingredients (APIs) refer to APIs manufactured through microbial fermentation processes. Microorganisms like bacteria, yeast, fungi, and algae are cultivated in large bioreactors to produce a variety of useful compounds like therapeutic enzymes, amino acids, antibiotics, hormones, and vitamins. While discovery of penicillin in the 1920s marked the genesis of modern antibiotics derived from microbial sources, research and commercial production of microbial APIs has significantly expanded since then. Today, over 150 different antibiotics along with various other APIs used in human and veterinary medicine are produced commercially via microbial fermentation worldwide.
Additionally, growing geriatric population suffering from chronic illnesses like cancer and cardiovascular diseases, which require long-term medication, has augmented the overall antibiotics consumption globally. On the geographical front, North America currently dominates the Microbial API share due to extensive R&D investments and generic drug manufacturing. However, Asia Pacific is witnessing fastest gains and is projected to surpass North America in terms of value by 2027 supported by low-cost manufacturing, increasing biotech investments, and favorable regulatory environment in China and India.
Penicillin Production Dynamics
Penicillin, the original microbial API breakthrough drug, still maintains a sizable share of the overall microbial API market. In 2020, global penicillin production was estimated at X million kilograms. While large pharmaceutical companies in Western Europe and North America held a dominant share for long, in recent years low-cost producers from Asia, especially China, have emerged as leading exporters of penicillin worldwide. Even though industrial scale penicillin manufacturing process has remained more or less same over the decades, fermentation and processing technologies have become more sophisticated with enhanced process automation, better bioreactor designs, and advanced quality control systems. This has improved product yields and consistency for many manufacturers. Additionally, Chinese players are aggressively expanding capacities through both organic and inorganic means to meet the rising generics demand and stock low-priced penicillin globally.
Emerging Segments
While conventional fermentation derived microbial APIs like various antibiotics continue dominating the market, new opportunities are opening up for novel biologics and vaccines produced by genetic modification of microbial host systems. For example, engineered E. coli or yeast are being used to express complex therapeutic proteins, monoclonal antibodies, and even viral vectors for gene and cell therapies. Also, with advancements in systems and synthetic biology, it is now possible to genetically program microbes to produce high-value small molecules that were historically extracted from natural sources or chemically synthesized. To name a few - 1) Amino acids produced by Corynebacterium glutamicum, 2) Taxol (anti-cancer drug) from genetically modified Saccharomyces cerevisiae, and 3) Cannabinoids (CBD, THC) from recombinant yeast. Going forward, this emerging segment of genetically and metabolically engineered microbial cell factories is anticipated to open new frontiers in drug discovery and large-scale manufacturing processes.
Outsourcing and Microbial API
Escalating R&D costs, regulatory complexities, and increased productivity demands have propelled many big pharmaceutical firms to outsource a significant part of their microbial API development and manufacturing activities to specialized contract manufacturing organizations (CMOs). The global microbial CMO market was valued at approximately USD X billion in 2020. Region-wise, North America and Europe currently lead as major outsourcing destinations, whereas India and China offer highly competitive services due to their process development and manufacturing expertise coupled with lower costs. Top global pharmaceutical companies are also augmenting in-house capabilities through strategic collaboration or acquisition of competent CMOs across different geographies. Overall, the outsourcing wave is opening up huge business potential for third-party microbial API/drug substance CMOs specialized in end-to-end services from process & analytical methods development to commercial scale production and quality testing.
Get More Insights on Microbial API
For Better understanding, choose preferred language-
• French
• German
• Italian
• Russian
• Japanese
• Chinese
• Korean
• Portuguese
About Author-
Ravina Pandya, Content Writer, has a strong foothold in the market research industry. She specializes in writing well-researched articles from different industries, including food and beverages, information and technology, healthcare, chemical and materials, etc. With an MBA in E-commerce, she has an expertise in SEO-optimized content that resonates with industry professionals. (https://www.linkedin.com/in/ravina-pandya-1a3984191)




Comments
There are no comments for this story
Be the first to respond and start the conversation.